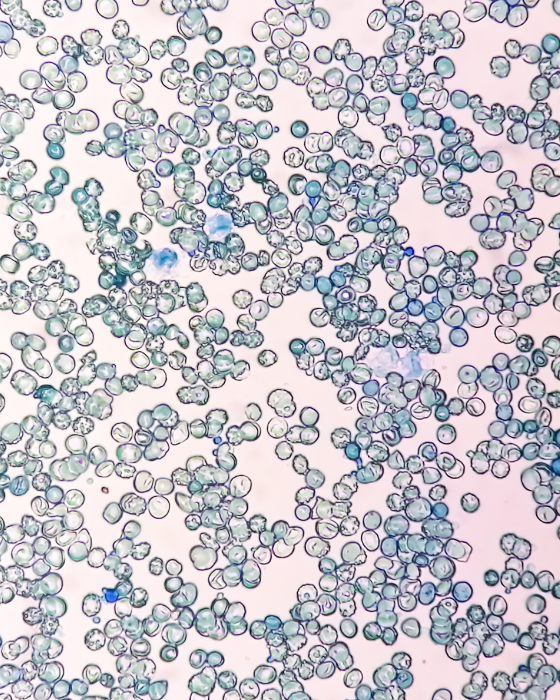

Υψηλή ποιότητα ιατρικής φροντίδας με την καλύτερη εξυπηρέτηση στον τομέα της αιματολογίας
Η Αιματολογική Κλινική του Νοσοκομείου Άγιος Ανδρέας λειτουργεί από το 1999, με στόχο την παροχή υψηλού επιπέδου φροντίδας σε ασθενείς με αιματολογικές διαταραχές. Η κλινική μας εξειδικεύεται στη διάγνωση και θεραπεία ενός ευρέος φάσματος αιματολογικών παθήσεων, με έμφαση στην εξατομικευμένη και ανθρώπινη φροντίδα. Η έμπειρη ομάδα αιματολόγων, νοσηλευτών και υποστηρικτικού προσωπικού εργάζεται αδιάκοπα για να διασφαλίσει ότι κάθε ασθενής λαμβάνει την καλύτερη δυνατή θεραπεία σε ένα φιλόξενο και υποστηρικτικό περιβάλλον.
30+
Χρόνια εμπειρίας
Θετική Επίδραση στην Υγεία
Επηρεάζουμε Σημαντικά Κάθε Τομέα Υγειονομικής Φροντίδας
Η Αποστολή μας
Ως ένα από τα σημαντικά κέντρα αιματολογικής φροντίδας στην περιοχή, η αποστολή μας είναι να παρέχουμε εξειδικευμένη και ολοκληρωμένη φροντίδα για μια ευρεία γκάμα αιματολογικών παθήσεων. Με προηγμένες τεχνολογίες και θεραπευτικές προσεγγίσεις, προσφέρουμε ακριβείς διαγνώσεις και καινοτόμες θεραπείες, διασφαλίζοντας την καλύτερη δυνατή υποστήριξη για κάθε ασθενή.
Το όραμα μας
Στοχεύουμε να ηγηθούμε στην εξειδικευμένη φροντίδα αιματολογικών παθήσεων μέσω καινοτόμων θεραπειών και συνεχούς έρευνας. Επικεντρωνόμαστε στην εξέλιξη των ιατρικών πρακτικών μας με σεβασμό προς τον ασθενή και με την υποστήριξη μιας ομάδας κορυφαίων ειδικών. Επιθυμούμε να προσφέρουμε μια ολοκληρωμένη και προσωπική προσέγγιση, εξασφαλίζοντας την καλύτερη ποιότητα ζωής για τους ασθενείς μας.
Η υπόσχεση μας
Η υπόσχεσή μας είναι να παρέχουμε άμεση και εξειδικευμένη φροντίδα με απόλυτη αφοσίωση στην υγεία και ευημερία των ασθενών μας. Δεσμευόμαστε να χρησιμοποιούμε προηγμένες ιατρικές τεχνολογίες και θεραπευτικές προσεγγίσεις, συνδυάζοντας επιστημονική αριστεία με ανθρώπινη ευαισθησία. Στόχος μας είναι να δημιουργήσουμε ένα υποστηρικτικό και συμπονετικό περιβάλλον, όπου κάθε ασθενής αισθάνεται σεβαστός και κατανοητός.
Τι λένε οι ασθενείς για εμάς
Οι ασθενείς μας αναγνωρίζουν την αφοσίωση και τη φροντίδα που παρέχουμε, εκτιμώντας την επαγγελματικότητα και την υποστήριξή μας κατά τη διάρκεια της θεραπείας τους. Οι θετικές τους εμπειρίες ενισχύουν τη δέσμευσή μας για ποιοτική φροντίδα.
η Ομάδα μας
Είμαστε μια ομάδα εξειδικευμένων επαγγελματιών που αφοσιώνονται στην καλύτερη φροντίδα των ασθενών μας.

Διευθυντής παθολογικού τομέα







